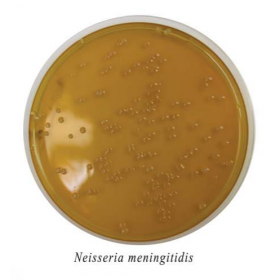
Менингоагар

Менингоагар
Менингоагар сухой
Питательная среда для культивирования менингококков и выделения их из клинического материала.
Данный продукт предназначен для исследовательских целей.
Фасовка 250 г для приготовления 6 л среды.
Срок годности 2 года.
- Стерильность: -
- Форма выпуска: Порошок
- Упаковка: 250 г
- Документы: Для исследовательских целей